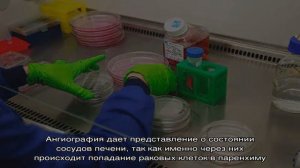
Метастазы в печени: прогноз продолжительности жизни

1:59
1:59
2024-04-25 22:17

 1:53
1:53

 1:53
1:53
2024-01-18 10:30

 1:09:09
1:09:09

 1:09:09
1:09:09
2024-09-13 12:45

 1:14:37
1:14:37

 1:14:37
1:14:37
2024-09-26 21:00

 4:49
4:49

 4:49
4:49
2025-09-06 20:06

 15:50
15:50

 15:50
15:50
2024-05-01 15:05

 22:49
22:49

 22:49
22:49
2025-09-10 20:31

 4:53
4:53

 4:53
4:53
2023-11-18 00:53

 6:56
6:56

 6:56
6:56
2023-11-18 01:38

 1:52
1:52

 1:52
1:52
2023-11-12 16:16

 10:55
10:55

 10:55
10:55
2024-08-14 18:53

 3:50
3:50

 3:50
3:50
2023-06-27 13:38

 4:15
4:15

 4:15
4:15
2025-05-12 09:23

 5:40
5:40

 5:40
5:40
2025-08-17 15:00

 16:53
16:53

 16:53
16:53
2025-09-07 19:37

 2:30
2:30

 2:30
2:30
2024-04-21 12:33

 10:23
10:23
10:23
10:23
2023-11-12 12:52

 10:00
10:00
![Антон Макарский - Не уходи (Премьера клипа 2025)]() 3:41
3:41
![Tamo ft Djan Edmonte - Ну что красавица (Премьера клипа 2025)]() 3:10
3:10
![Соня Белькевич, Олег Семенов - Увы, мадам (Премьера 2025)]() 3:33
3:33
![A'Studio – Она не виновата (Премьера клипа 2025)]() 2:13
2:13
![Азамат Ражабов - Нигорим (Премьера клипа 2025)]() 3:52
3:52
![Маракеш, Сергей Наговицын - До свидания, кореша (Премьера клипа 2025)]() 3:20
3:20
![Мухит Бобоев - Маликам (Премьера клипа 2025)]() 3:18
3:18
![Like Nastya – Fly Girl (Official Video 2025)]() 2:01
2:01
![Соня Белькевич, КРЕСТОВ - Малиновый закат (Премьера клипа 2025)]() 3:24
3:24
![Бобур Ахмад - Куролмаслар (Премьера клипа 2025)]() 3:33
3:33
![Илёс Юнусий - Каранг она якинларим (Премьера клипа 2025)]() 3:36
3:36
![Сирожиддин Шарипов - Хазонлар (Премьера клипа 2025)]() 3:09
3:09
![Magas - Только ты (Премьера клипа 2025)]() 3:04
3:04
![Абдуллах Борлаков, Мекка Борлакова - Звездная ночь (Премьера клипа 2025)]() 4:25
4:25
![МАРАТ & АРНИ - Я ЖЕНИЛСЯ (Премьера клипа 2025)]() 4:16
4:16
![Руслан Добрый - Тёплые края (Премьера клипа 2025)]() 2:14
2:14
![Жамхур Хайруллаев - Битта дона (Премьера клипа 2025)]() 2:49
2:49
![Bruno Mars ft. Ed Sheeran – Home to You (Official Video 2025)]() 3:25
3:25
![Gulinur - Nishatar (Official Video 2025)]() 3:40
3:40
![Иброхим Уткиров - Коракуз (Премьера клипа 2025)]() 4:28
4:28
![Большой Лебовски | The Big Lebowski (1998) (Гоблин)]() 1:56:59
1:56:59
![Вальсируя с Брандо | Waltzing with Brando (2024)]() 1:44:15
1:44:15
![Плохой Cанта 2 | Bad Santa 2 (2016) (Гоблин)]() 1:28:32
1:28:32
![Заклятие 4: Последний обряд | The Conjuring: Last Rites (2025)]() 2:15:54
2:15:54
![Терминатор 2: Судный день | Terminator 2: Judgment Day (1991) (Гоблин)]() 2:36:13
2:36:13
![Бешеные псы | Reservoir Dogs (1991) (Гоблин)]() 1:39:10
1:39:10
![Гедда | Hedda (2025)]() 1:48:23
1:48:23
![Богомол | Samagwi (2025)]() 1:53:29
1:53:29
![Крысы: Ведьмачья история | The Rats: A Witcher Tale (2025)]() 1:23:01
1:23:01
![Свайпнуть | Swiped (2025)]() 1:50:35
1:50:35
![Порочный круг | Vicious (2025)]() 1:42:30
1:42:30
![Баллада о маленьком игроке | Ballad of a Small Player (2025)]() 1:42:60
1:42:60
![Трон: Арес | Tron: Ares (2025)]() 1:52:27
1:52:27
![Грязь | Filth (2013) (Гоблин)]() 1:37:25
1:37:25
![Крушащая машина | The Smashing Machine (2025)]() 2:03:12
2:03:12
![От заката до рассвета | From Dusk Till Dawn (1995) (Гоблин)]() 1:47:54
1:47:54
![Школьный автобус | The Lost Bus (2025)]() 2:09:55
2:09:55
![Чумовая пятница 2 | Freakier Friday (2025)]() 1:50:38
1:50:38
![Рука, качающая колыбель | The Hand That Rocks the Cradle (2025)]() 1:44:57
1:44:57
![Свинтусы | The Twits (2025)]() 1:42:50
1:42:50
![Котёнок Шмяк]() 11:04
11:04
![Карли – искательница приключений. Древнее королевство]() 13:00
13:00
![Космический рейнджер Роджер Сезон 1]() 11:32
11:32
![МиниФорс Сезон 1]() 13:12
13:12
![Роботы-пожарные]() 12:31
12:31
![Корги по имени Моко. Защитники планеты]() 4:33
4:33
![Панда и петушок Лука]() 12:12
12:12
![Приключения Пети и Волка]() 11:00
11:00
![Ну, погоди! Каникулы]() 7:09
7:09
![Крутиксы]() 11:00
11:00
![Псэмми. Пять детей и волшебство Сезон 1]() 12:17
12:17
![Кадеты Баданаму Сезон 1]() 11:50
11:50
![Сборники «Зебра в клеточку»]() 45:30
45:30
![Пип и Альба Сезон 1]() 11:02
11:02
![Таинственные золотые города]() 23:04
23:04
![Простоквашино]() 6:48
6:48
![Мотофайтеры]() 13:10
13:10
![Агент 203]() 21:08
21:08
![Рэй и пожарный патруль Сезон 1]() 13:27
13:27
![Паровозик Титипо]() 13:42
13:42

 10:00
10:00Скачать видео
| 144x256 | ||
| 240x426 | ||
| 360x640 | ||
| 480x854 | ||
| 720x1280 |
 3:41
3:41
2025-11-05 11:55
 3:10
3:10
2025-11-07 13:57
 3:33
3:33
2025-11-07 15:10
 2:13
2:13
2025-10-31 12:53
 3:52
3:52
2025-11-07 14:08
 3:20
3:20
2025-11-11 00:28
 3:18
3:18
2025-11-02 10:30
 2:01
2:01
2025-11-10 13:14
 3:24
3:24
2025-11-07 14:37
 3:33
3:33
2025-11-02 10:17
 3:36
3:36
2025-11-02 10:25
 3:09
3:09
2025-11-09 16:47
 3:04
3:04
2025-11-05 00:49
 4:25
4:25
2025-11-07 13:49
 4:16
4:16
2025-11-06 13:11
 2:14
2:14
2025-11-05 00:29
 2:49
2:49
2025-11-06 13:20
 3:25
3:25
2025-11-02 10:34
 3:40
3:40
2025-10-31 13:38
 4:28
4:28
2025-11-03 15:38
0/0
 1:56:59
1:56:59
2025-09-23 22:53
 1:44:15
1:44:15
2025-11-07 20:19
 1:28:32
1:28:32
2025-10-07 09:27
 2:15:54
2:15:54
2025-10-13 19:02
 2:36:13
2:36:13
2025-10-07 09:27
 1:39:10
1:39:10
2025-09-23 22:53
 1:48:23
1:48:23
2025-11-05 19:47
 1:53:29
1:53:29
2025-10-01 12:06
 1:23:01
1:23:01
2025-11-05 19:47
 1:50:35
1:50:35
2025-09-24 10:48
 1:42:30
1:42:30
2025-10-14 20:27
 1:42:60
1:42:60
2025-10-31 10:53
 1:52:27
1:52:27
2025-11-06 18:12
 1:37:25
1:37:25
2025-09-23 22:52
 2:03:12
2:03:12
2025-11-07 20:11
 1:47:54
1:47:54
2025-09-23 22:53
 2:09:55
2:09:55
2025-10-05 00:32
 1:50:38
1:50:38
2025-10-16 16:08
 1:44:57
1:44:57
2025-10-29 16:30
 1:42:50
1:42:50
2025-10-21 16:19
0/0
 11:04
11:04
2023-05-18 16:41
 13:00
13:00
2024-11-28 16:19
2021-09-22 21:49
2021-09-23 00:15
2021-09-23 00:12
 4:33
4:33
2024-12-17 16:56
 12:12
12:12
2024-11-29 14:21
 11:00
11:00
2022-04-01 17:59
 7:09
7:09
2025-08-19 17:20
 11:00
11:00
2022-07-25 18:59
2021-09-22 22:23
2021-09-22 21:17
 45:30
45:30
2025-09-17 18:49
2021-09-22 23:37
 23:04
23:04
2025-01-09 17:26
 6:48
6:48
2025-10-17 10:00
 13:10
13:10
2024-11-27 14:57
 21:08
21:08
2025-01-09 16:39
2021-09-22 23:51
 13:42
13:42
2024-11-28 14:12
0/0

